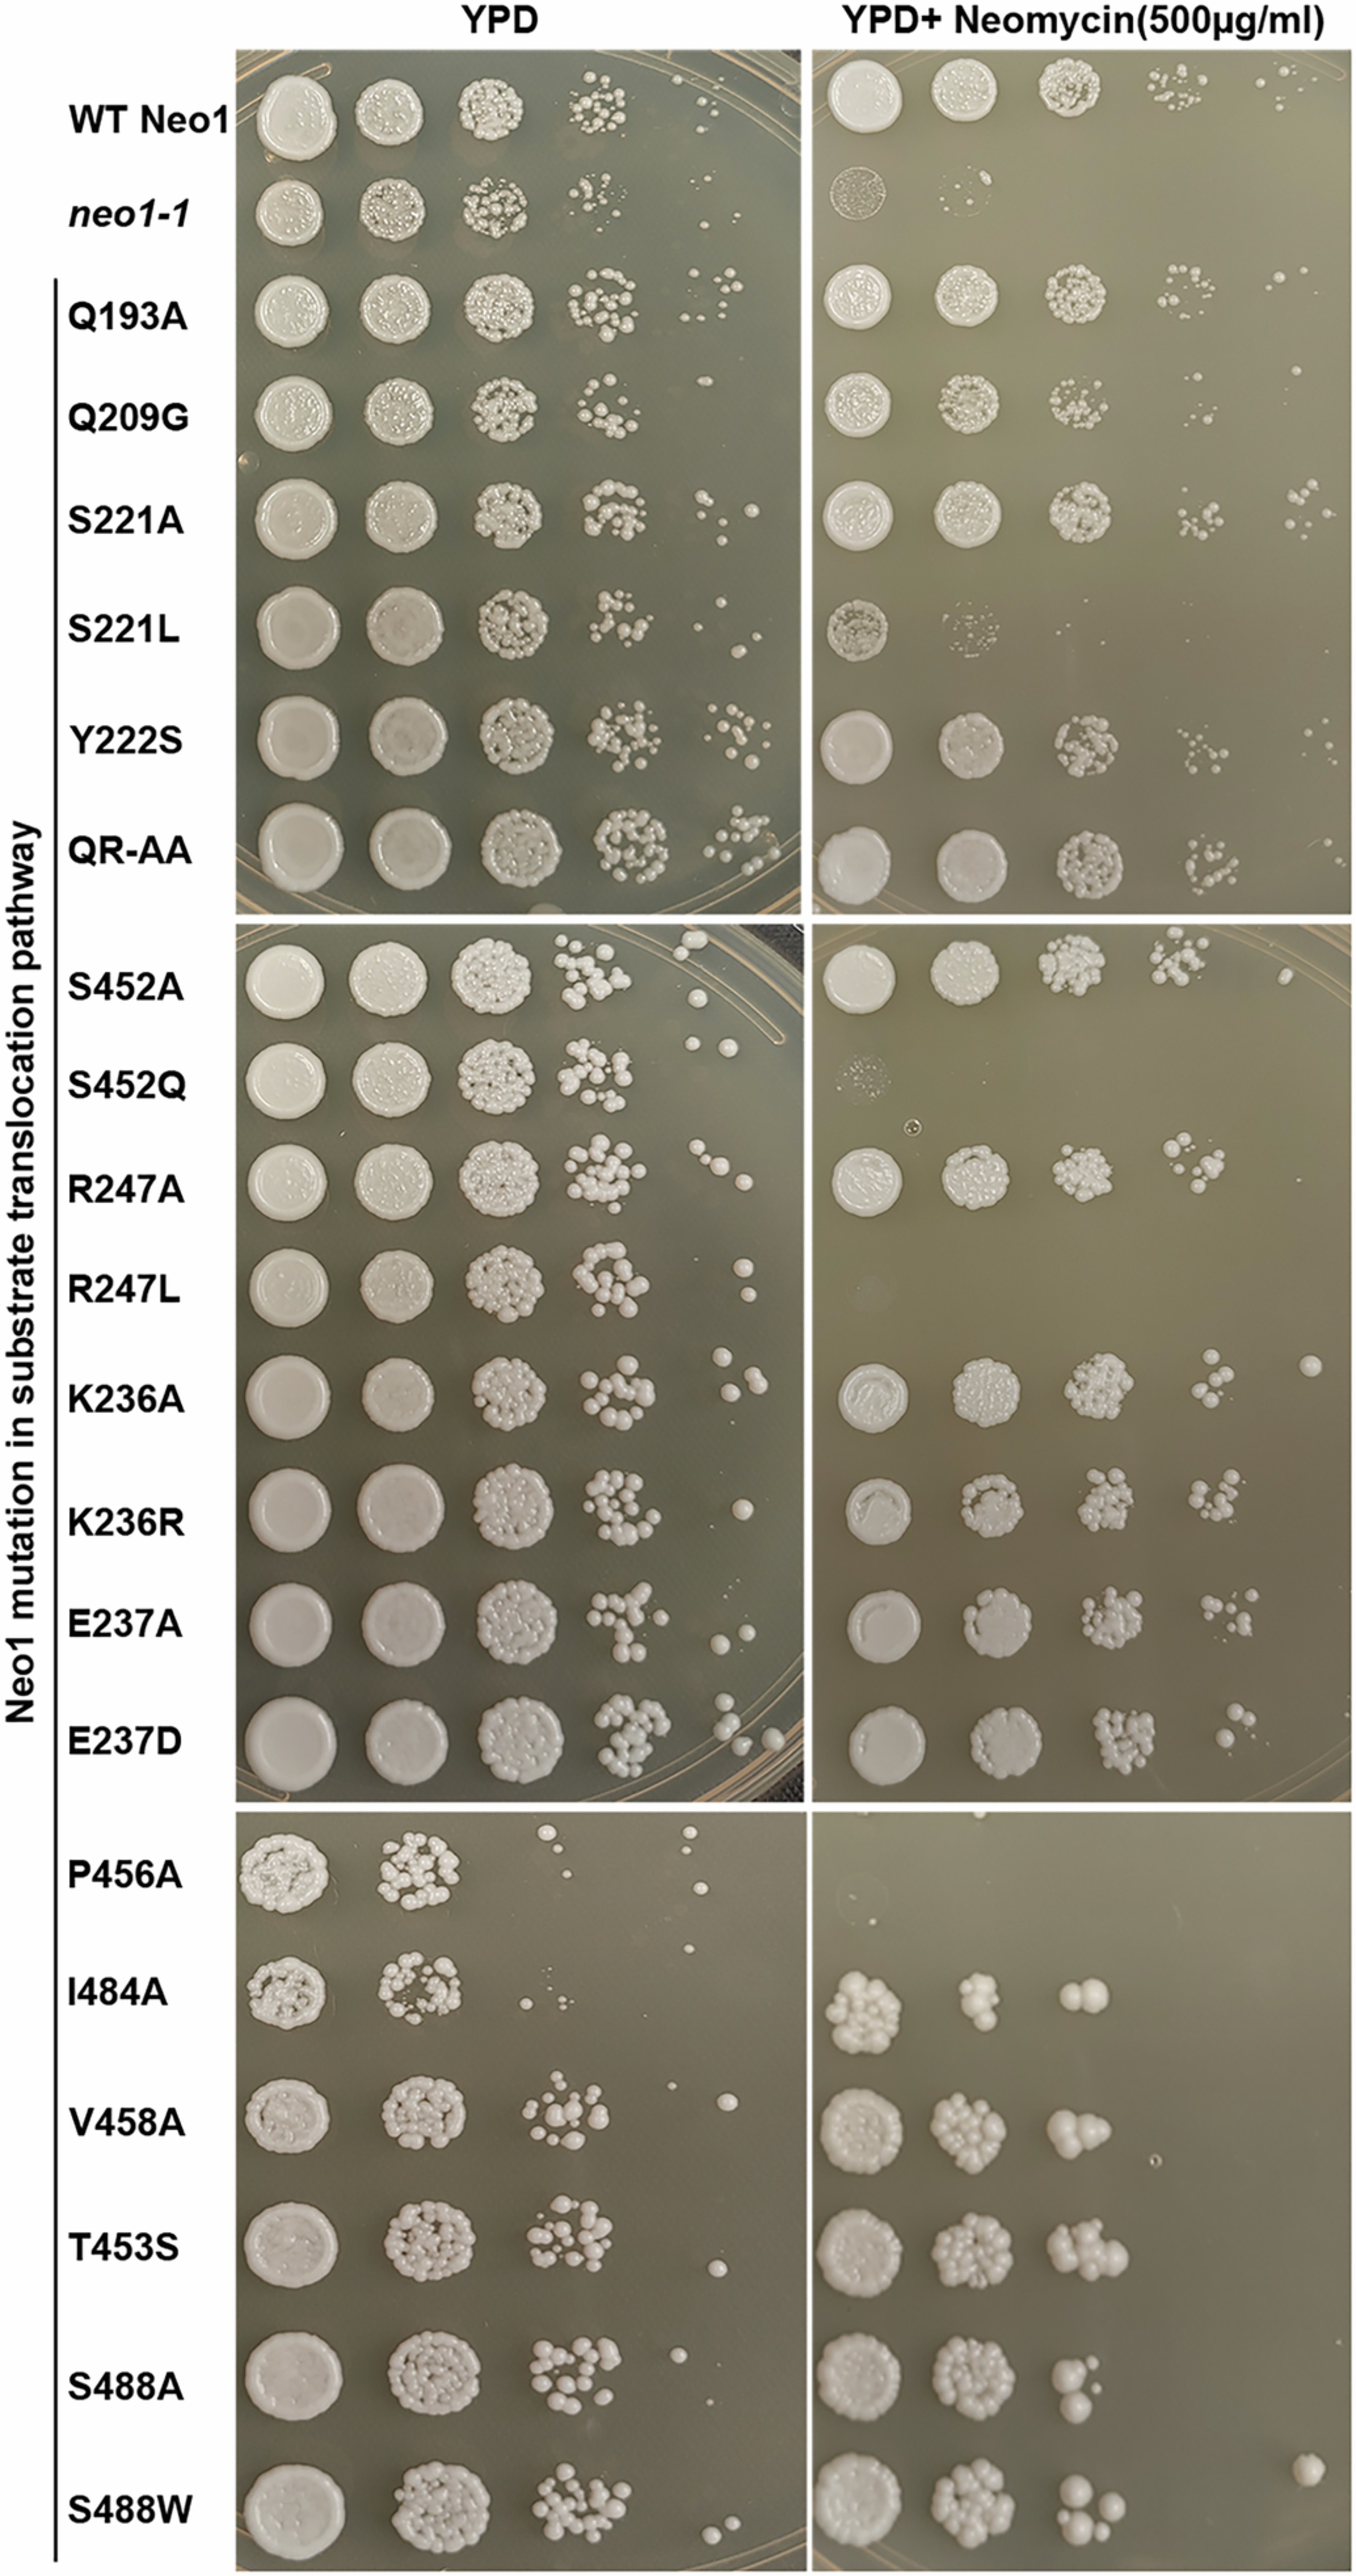
Extended Data Fig. 1: Neo1 substrate transport pathway mutants are sensitive to neomycin.

Extended Data Fig. 1: Neo1 substrate transport pathway mutants are sensitive to neomycin.
From: P4-ATPases control phosphoinositide membrane asymmetry and neomycin resistance
Neomycin sensitivity assay of neo1 substrate transport pathway mutants at 26 °C on YPD and YPD Neomycin (500 µg/ml) plates.